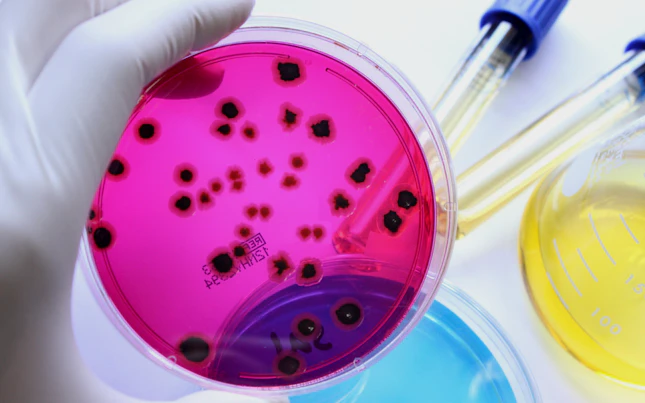
Microbios en una placa de vidrio de prueba

Protege tu marca minimizando los riesgos en tu cadena de suministro con nuestros servicios globales de conformidad, capacitación, pruebas, inspección, auditoría y certificación.
El acceso de los productos alimentarios a los mercados mundiales puede ser complejo. Cada mercado tiene sus propias exigencias, ya sean los gustos y demandas de los consumidores o las normativas sobre seguridad, calidad y sostenibilidad.
Ofrecemos una amplia gama de servicios de garantía y asesoramiento para ayudar a las empresas alimentarias a suministrar productos de alta calidad, seguros y conformes a las normas a los mercados de todo el mundo. Nuestra red mundial de expertos en alimentación, que incluye auditores altamente calificados y especialistas en seguridad alimentaria, y que utiliza laboratorios y aplicaciones informáticas de última generación, proporciona soluciones independientes que cubren todas tus necesidades de conocimiento, gestión de riesgos y cumplimiento de la normativa.
Ofrecemos una amplia gama de soluciones de pruebas conforme a normas reconocidas internacionalmente. Nuestros analistas altamente calificados y expertos en la industria se asegurarán de que tus productos cumplan las expectativas de los clientes y los requisitos establecidos por los organismos de acreditación y los gobiernos. Desde análisis microbiológicos esenciales hasta pruebas de autenticidad, nutrición o alérgenos alimentarios, nuestros expertos procesarán tus muestras con rapidez, profesionalidad y precisión. Además, nuestros revisores de etiquetas alimentarias pueden garantizar que las declaraciones y etiquetas de tus productos cumplen los requisitos normativos.
Ofrecemos una amplia gama de servicios de auditoría y certificación en mercados de todo el mundo, lo que garantiza que tu cadena de suministro se ajuste a las normas locales e internacionales. Además, ofrecemos inteligencia de mercado de alto nivel sobre una serie de sectores alimentarios y un servicio de análisis del horizonte para obtener actualizaciones normativas y predicciones del riesgo de los productos mediante inteligencia artificial.
SGS es líder mundial en la provisión de capacitación profesional, lo que te da acceso a soluciones innovadoras de aprendizaje y desarrollo que te ayudan a evaluar y mejorar tus estándares de calidad y seguridad alimentaria. Nuestros cursos cubren todos los aspectos de tu cadena de valor alimentaria, incluida la sostenibilidad, y pueden impartirse en diversos formatos, incluidos el virtual y el electrónico.
Con una red mundial de especialistas en todos los mercados, nuestros servicios te ayudan a generar confianza en tus cadenas de suministro alimentario.
¿Busca algo en particular?
Buscar en Alimentos